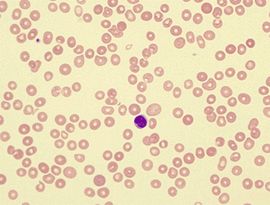
中度貧血 中度貧血

目錄
簡介
中度貧血的症狀
貧血的原因
貧血要多吃的食物
日常生活的注意事項
簡介
臨床上根據血紅蛋白量和紅細胞數降低程度的不同而將貧血分為以下幾度:血紅蛋白在9-12克/分升為輕度,6-9克/分升為中度,3-6克/分升為重度,3克/分升以下為極重度。紅細胞數在300萬-400萬/立方毫米(以下單位同)為輕度,200萬-300萬為中度,100萬-200萬為重度,100萬以下為極重度。也就是中度貧血的血紅蛋白為6-9克/分升,紅細胞數200萬-300萬萬/立方毫米。
中度貧血的症狀
中度的貧血時,不管是休息或運動時都容易出現出現心悸、呼吸困難、頭暈等心肺方面的問題。
貧血的原因
一、造血不良貧血
(紅細胞生成減少)
(一)血紅蛋白合成障礙
1.缺鐵性貧血:鐵攝入不足、鐵需要量相對增加(妊娠、兒童生長發育期)鐵吸收障礙(慢性胃腸道疾病、胃大部切除術後),慢性失血。
2.鐵粒幼細胞性貧血。
3.維生素B6反應性貧血。
4.載鐵蛋白缺乏性貧血。
(二)核成熟障礙
1.惡性貧血。
2.其他原因致葉酸及或維生素Bl2。缺乏利用障礙引起的巨幼細胞貧血:營養不良(食物中缺乏、嬰幼兒哺育不當、長期酗酒、頑固性厭食〉、需要量增加(妊娠、哺乳期、兒童生長發育期、闊節裂頭絛蟲感染、溶血、感染、甲狀腺功能亢進症等〉、吸收不良(全胃或胃大部切除術後、慢性萎縮性胃炎、胃癌、慢性肝病、慢性腸炎、吸收不良綜合徵、腸切除術後、腸憩室細菌感染〉、藥物對核酸代謝的影響(如抗葉酸劑、抗驚厥藥、抗結核藥、口服避孕藥、新黴素、亞硝酸鹽等)。
(三)骨髓造血功能減低
1.幹細胞缺陷
(1)再生障礙性貧血。
(2)先天性再生障礙性貧血。
(3)純紅細胞再生障礙性貧血。
(4)骨髓增殖異常綜合徵。
2.骨髓造血組織被其他細胞擠占白血病、惡性淋巴瘤、多發性骨髓瘤、骨髓轉移癌、骨髓纖維化、系統性肥大細胞增多症、大理石骨病等。
3.紅細胞生成調節因子缺陷腎性貧血、內分泌腺(如垂體、甲狀腺)功能低下、感染性貧血等。
二、失血性貧血
(一)急性失血性貧血
如創傷致大量外出血或內臟破裂大出血、宮外孕、胃腸大出血等。
(二)慢性失血性貧血
如月經過多、痔出血、鉤蟲病、胃癌、消化性潰瘍等。
三、溶血性貧血(紅細胞破壞過多)
(一)紅細胞內在缺陷
1.先天遺傳性
(1)紅細胞膜異常:遺傳性球形細胞增多症、遺傳性橢圓形細胞增多症、遺傳性口形細胞增多症。
(2)紅細胞酶異常:糖無氧酵解中酶的缺陷(如丙酮酸激酶缺乏症)磷酸己糖旁路中酶的缺乏(~磷酸葡萄糖脫氫酶缺乏症,常因服蠶豆、伯氨喹等氧化藥物或感染誘發溶血;其他有關成分缺乏所致的溶血性貧血)。
(3)珠蛋白鏈異常:肽鏈量的異常(Q地中海貧血、B地中海貧血)、肽鏈結構異常(聚合性血紅蛋白病、不穩定血紅蛋白病)。
2.後天獲得性陣發性睡眠性血紅蛋白尿(PNH)。
(二)紅細胞外在因素
1.免疫性
(1)自身免疫性:溫抗體型(急性特發性獲得性溶血性貧血、慢性特發性溫暖型抗體免疫性溶血性貧血、症狀性溫暖型抗體免疫性溶血
性貧血)冷抗體型(特發性慢性冷凝集素病、陣發性寒冷性血紅蛋白尿、症狀性冷凝集素病人)。
(2)同種免疫性:新生兒溶血病、ABO血型不合溶血性輸血反應、Rh血型不合溶血性輸血反應。
(3)藥物免疫性溶血性貧血:可見於對氨水楊酸、異煙姘、利福平、奎尼丁、非那西了、氨基比林、磺胺類藥、氯丙嗪、氯磺雨脲、胰島素、青黴素、頭孢菌素等。
2.非免疫性
(1)機械因素(紅細胞碎片綜合徵):微血管病性溶血性貧血及人工心臟瓣膜置換術後溶血性貧血。
(2)感染性溶血性貧血:瘧疾、敗血症等。
(3)生物因素所致溶血性貧血;蛇毒、毒蕈等。
(4)藥物及化學品所致溶血性貧血。
(5)脾功能亢進。
(6)彌散性血管內凝血(DIC)
(7)電離輻射。
貧血要多吃的食物
黑豆:我國古時向來認為吃豆有益,多數書上會介紹黑豆可以讓人頭髮變黑,其實黑豆也可以生血。黑豆的吃法隨各人喜好,如果是在產後,建議用黑豆煮烏骨雞。
髮菜:髮菜的顏色很黑,不好看,但髮菜內所含的鐵質較高,用髮菜煮湯做菜,可以補血。
胡蘿蔔:胡蘿蔔含有很高的維生素B、C,同時又含有一種特別的營養素-胡蘿蔔素,胡蘿蔔素對補血極有益,用胡蘿蔔煮湯,是很好的補血湯飲。不過許多人不愛吃胡蘿蔔,我個人的做法是把胡蘿蔔榨汁,加入蜂蜜當飲料喝。
麵筋:這是種民間食品。一般的素食館、滷味攤都有供應,麵筋的鐵質含量相當豐富。而補血必須先補鐵。
菠菜:這是最常見的蔬菜。也是有名的補血食物,菠菜內含有豐富的鐵質胡蘿蔔素,所以菠菜可以算是補血蔬菜中的重要食物。如果不愛吃胡蘿蔔,那就多吃點菠菜吧。
金針菜:金針菜含鐵數量最大,比大家熟悉的菠菜高了20倍,鐵質含量豐富,同時金針菜還含有豐富的維生素A、B1、C、蛋白質、脂肪及秋水仙醉鹼等營養素。
龍眼肉:龍眼肉就是桂圓肉,任何一家超市都有售。龍眼肉除了含豐富的鐵質外還含有維生素A、B和葡萄糖、蔗糖等。補血的同時還能治療健忘、心悸、神經衰弱和失眠症。龍眼湯、龍眼膠、龍眼酒之類也是很好的補血食物。
蘿蔔乾:蘿蔔乾本來就是有益的蔬菜,它所含的維生素B極為豐富,鐵質含量很高。所以它是最不起眼最便宜但卻是最好的養生食物,它的鐵質含量除了金針菜之外超過一切食物。
含鐵豐富的食物還有蛋黃、瘦肉、魚、禽類、豆類、動物肝、腎、心、血、芹菜、大頭菜、黑木耳、大棗、蘿蔔、南瓜、馬鈴薯、菜花、甘藍、桔子、葡萄、檸檬等。
日常生活的注意事項
(1)飲食調攝:飲食營養要合理,食物必須多樣化,食譜要廣,不應偏食,否則會因某種營養素的缺乏而引起貧血。要富有營養及易於消化,飲食應有規律,有節制,嚴禁暴飲暴食。多食含鐵豐富的食物,如豬肝、豬血、瘦肉、奶製品、豆類、大米、蘋果、綠葉蔬菜等。多飲茶能補充葉酸,維生素B12,有利於巨細胞性貧血的治療。但缺鐵性貧血則不宜飲茶,因為飲茶不利於人體對鐵劑的吸收。適當補充酸性食物則有利於鐵劑的吸收。忌食辛辣,生冷不易消化的食物。平時可配合滋補食療以補養身體。
(2)勞逸結合,進行適當的體育活動。
(3)鐵是血紅蛋白的組成成分,血紅蛋白參與氧的運輸和存儲。由於體內鐵的儲存不能滿足正常紅細胞生成的需要而發生的貧血稱為缺鐵性貧血,一般會在持續缺鐵3~5個月時發生。補充鐵劑,一定要與餐共食或餐後服用,可以降低鐵質對腸胃的刺激性,同時食物中的蛋白質,更可以提高鐵質的吸收率,如果能夠隨富含維生素C的水果或果汁服用,吸收率會更佳。
(4)貧血者最好不要喝茶,多喝茶只會使貧血症狀加重。因為食物中的鐵,是以3價膠狀氫氧化鐵形式進入消化道的。經胃液的作用,高價鐵轉變為低價鐵,才能被吸收。可是茶中含有鞣酸,飲後易形成不溶性鞣酸鐵,從而阻礙了鐵的吸收。其次,牛奶及一些中和胃酸的藥物會阻礙鐵質的吸收,所以儘量不要和含鐵的食物一起食用。
五個治療貧血食療驗方
治療貧血食療驗方之雞汁粥
【原料】母雞1隻(約1000g),粳米60g。
【製作方法】將雞宰殺洗淨,熬煮雞湯。以原汁雞湯分次同粳米煮粥。先用旺火煮沸,之後改用微火煎煮成粥。本粥適合早晚餐食用。
【特點】雞肉味甘、微溫,能溫中補脾,益氣養血,補腎益精。而且,雞肉含較高的蛋白質,其中的脂肪以不飽和脂肪酸為主。以雞煎汁同粳米用則有補脾益陰,養血強體作用。主治年幼體弱,氣血不足,營養不良。
治療貧血食療驗方之鹿角膠粥
【原料】鹿角膠5~15g,粳米60g,生薑3片。
【製作方法】先將粳米煮成粥,待沸時加入鹿角膠,生薑一同煮為粥。本粥適合冬季服食,3~5天為一療程。
【特點】鹿角膠為鹿角煎熬濃縮而成的膠體,味鹹,性微溫,有補腎陽、益陰血的作用。用於治氣血兩虧,病後體弱的虛寒證者。
治療貧血食療驗方之脊肉粥
【原料】豬脊肉100g,粳米100g,食鹽、香油、川椒(四川產的花椒)粉各少許。
【製作方法】先將豬脊瘦肉洗淨,切成小塊,用香油先炒一下,然後加入粳米煮粥,待粥成時,加入調味品,再煮沸即可。本粥可作為早餐食用,量不限,且粥性味平和,一般人均可服食,但不宜選用肥肉熬粥。
【特點】脊肉是指豬脊背上的精肉,古代醫家便把它作為藥用。脊肉味甘、性平。豬脊肉中含有豐富的蛋白質,高達17%,並含較多的鈣磷、鐵等營養成分。因此用豬脊肉同米煮粥,加入調味品,不但其味鮮美,而且補益人體。可治療體質虧損,脾虛血弱。
治療貧血食療驗方之韭菜炒羊肝
【原料】韭菜100g,羊肝120g。
【製作方法】將韭菜、羊肝洗淨,韭菜切小段,羊肝去筋膜,切片。起鍋加油、調料,旺火急炒,至熟即可。本菜可佐餐食用,間食之。
【特點】羊肝性味甘平,善於補血益肝明目。韭菜味甘辛,性溫,能補腎助陽,溫中開胃,主要含有揮髮油、硫化物、苷類、蛋白質及鈣、磷、鐵等成分。用於治療血虛面色萎黃,肝虛血少,視力減退。
治療貧血食療驗方之烏雞參芪湯
【原料】烏雞肉150g,黨參、北芪各30g。
【製作方法】烏雞肉洗淨,沸水稍浸,除去血腥味,然後切塊。將黨參北芪洗後用紗布裝好,加調料與雞肉置燉盅,隔水清燉。飲湯食肉,適宜晚餐後食用。
【特點】烏雞補益氣血,與黨參同用可益氣之陰,與北芪同用可補氣之陽,因此,本膳可益氣補血。治療氣血雙虧,脾胃不健,食少便溏,腎弱發育不佳。
市場上補鐵產品對比
1.產品:硫酸亞鐵緩釋片
生產企業:吉林精優美長白山藥業
口感:腥味重
補鐵效果:亞鐵製劑,補鐵吸收率一般
腸胃刺激:1.可見胃腸道不良反應,如噁心、嘔吐、上腹疼痛、便秘。 2.本品可減少腸蠕動,引起便秘,並排黑便。
安全性:鐵含量過高,不適合長期服用,過量補鐵易出現中毒,安全性低。
2.產品:鐵之緣片(乳酸)
生產企業:濟南體恆健生物工程有限公司
外觀口感:鐵之緣片蛋卷味、略帶甜味
補鐵效果:吸收利用率高,補鐵增加營養
腸胃刺激:不需要胃酸轉換,直接在腸道中被吸收
安全性:補鐵溫和無刺激,微量補充,適宜長期服用,安全性高。
3.產品:多糖鐵複合物膠囊 (力蜚能)
生產企業:珠海許瓦茲製藥有限公司
口感:無味、無臭
補鐵效果:吸收利用率高
腸胃刺激:極少出現胃腸刺激或便秘,偶有大便變為黑色或者綠色等
安全性:鐵含量高,不適合長期服用,膠囊寶寶不適宜服用,安全性高。
4.產品:葡萄糖酸亞鐵片
生產企業:開封康諾藥業
口感:酸中帶甜,有澀味。
補鐵效果:吸收率一般,副作用略小
腸胃刺激:含有酸根,有刺激副作用,如出現拉肚子、大便或牙齒變黑等
安全性:不適於長期服用,安全性中
5.產品:琥珀酸亞鐵顆粒(速力菲)
生產企業:金陵藥業
口感:鐵腥味濃
補鐵效果:吸收效果一般
腸胃刺激:可見胃腸道不良反應,如噁心、嘔吐、上腹疼痛、便秘。本品可減少腸蠕動,引起便秘,並排黑便。
安全性:不適於長期服用。
6.產品:多維鐵口服液
生產企業:湖南康壽製藥
口感:有腥味
補鐵效果:效果一般
腸胃刺激:1.可見胃腸道反應,如噁心、嘔吐、上腹部疼痛及便秘。 2.可致便秘和黑便。 3.長期過量服用可引起草酸鹽或尿酸鹽結石。
安全性:不適宜長期服用。安全性低
7.產品:右鏇糖酐鐵片
生產企業:
外觀:天津懷仁製藥
口感:含有鐵鏽味道
補鐵效果:補鐵吸收率一般
腸胃刺激:1.可見胃腸道不良反應,如噁心、嘔吐、上腹疼痛、便秘。 2.該藥品可減少腸蠕動,引起便秘,並排黑便。
孕婦中度貧血處理
飲食調理
孕婦貧血最好的方式就是食補多吃含鐵豐富的食物。多吃富鐵食物 ,多吃瘦肉、家禽、動物肝及血、蛋類、豆製品等富鐵食物。
多吃富葉酸食物 如肝臟、腎臟、綠葉蔬菜及魚、蛋、谷、豆製品、堅果等。注意烹調不要溫度過高,時間不要太長。維生素A對鐵的吸收及利用有一定幫助。同時多吃有助於鐵吸收的食物,水果和蔬菜所含的維生素C還可以促進鐵在腸道的吸收。
藥物調理
對於中度貧血的孕婦,口服鐵劑治療也是十分必要的,像華納鐵質葉酸片就很適合孕期的女性朋友服用。孕期貧血除服鐵劑以外,服用小劑量的葉酸(每日400ug),可以選擇葉酸片 (斯利安),孕婦專用。
也可給孕婦補充阿膠,但是中度貧血的孕婦在選擇阿膠的時候也有很多講究,如阿膠原粉,另外小編在這給大家推薦幾款比較信得過的阿膠,例如,人參阿膠漿、阿膠補血膏等等。